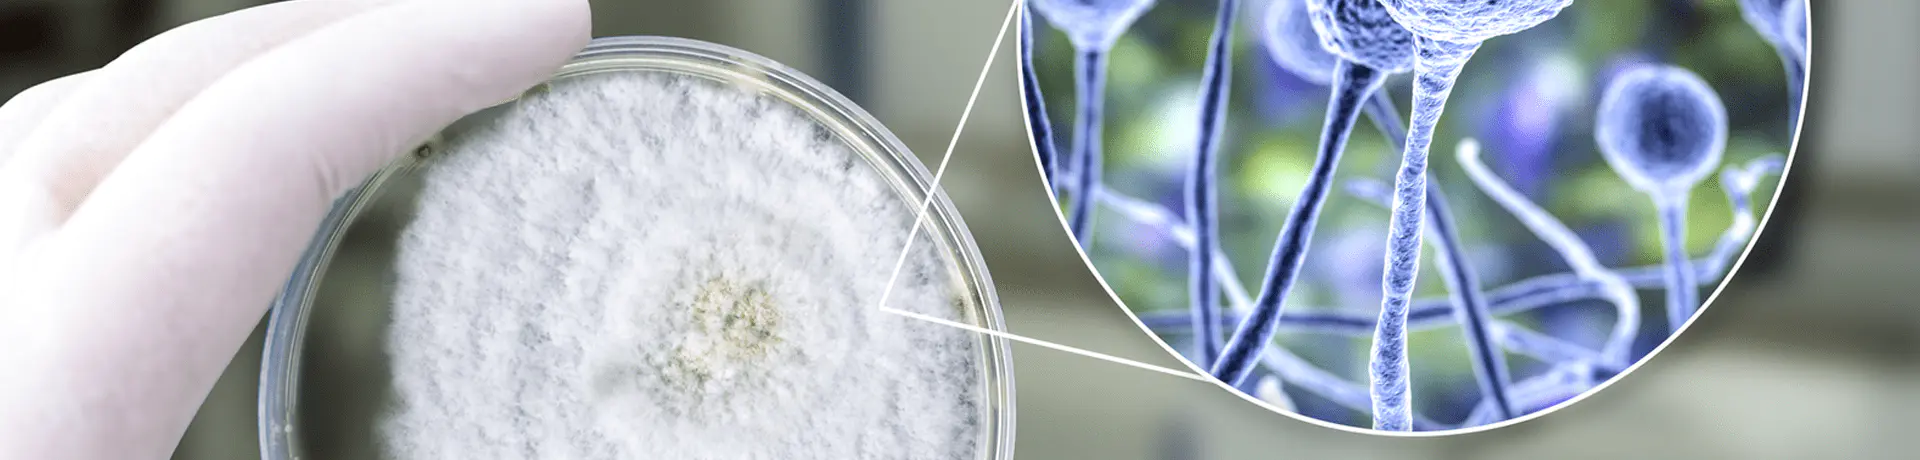

什么是培养皿?
查看回答
培养皿是一种用于微生物或细胞培养的实验室器皿,它由一个圆盘状的底和一个盖组成,基本用玻璃或塑料制成。玻璃的多用于植物材料、微生物培养和动物细胞的贴壁培养。塑料的大多数是聚乙烯材料的,有一次性的和多次使用的,适合实验室的接种、划线、分离细菌的操作,可以用于植物材料的培养。
什么是培养皿?
查看回答
培养皿是一种用于微生物或细胞培养的实验室器皿,它由一个圆盘状的底和一个盖组成,基本用玻璃或塑料制成。玻璃的多用于植物材料、微生物培养和动物细胞的贴壁培养。塑料的大多数是聚乙烯材料的,有一次性的和多次使用的,适合实验室的接种、划线、分离细菌的操作,可以用于植物材料的培养。
什么是培养皿?
查看回答
培养皿是一种用于微生物或细胞培养的实验室器皿,它由一个圆盘状的底和一个盖组成,基本用玻璃或塑料制成。玻璃的多用于植物材料、微生物培养和动物细胞的贴壁培养。塑料的大多数是聚乙烯材料的,有一次性的和多次使用的,适合实验室的接种、划线、分离细菌的操作,可以用于植物材料的培养。
什么是培养皿?
查看回答
培养皿是一种用于微生物或细胞培养的实验室器皿,它由一个圆盘状的底和一个盖组成,基本用玻璃或塑料制成。玻璃的多用于植物材料、微生物培养和动物细胞的贴壁培养。塑料的大多数是聚乙烯材料的,有一次性的和多次使用的,适合实验室的接种、划线、分离细菌的操作,可以用于植物材料的培养。